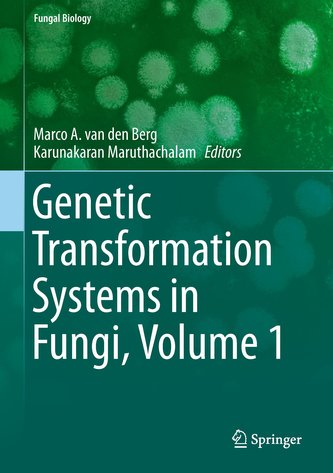
Genetic Transformation Systems in Fungi, Volume 1

Košík
zboží
(prázdné)
1.
1.
 Sběratelská záložka je součástí série.
Sběratelská záložka je součástí série.
 Pro dlouhou životnost je záložka potažená lesklou laminací, která zabraňuje poškození.
Pro dlouhou životnost je záložka potažená lesklou laminací, která zabraňuje poškození.
 Dárek získáte ke každé objednávce.
Dárek získáte ke každé objednávce.




Navrhněte maximálně 5 klíčových slov (štítků) k tomuto produktu.
Za každý přidaný štítek musíte poté 5x ohodnotit štítky ostatních.
Nezapomeňte navrhnuté štítky uložit stisknutím tlačítka „Uložit přidané štítky“.





 celková spokojenost
celková spokojenostAlkohol mohou nakupovat pouze osoby starší 18 let.
Prosím potvrďte, že Vám již bylo 18 let.